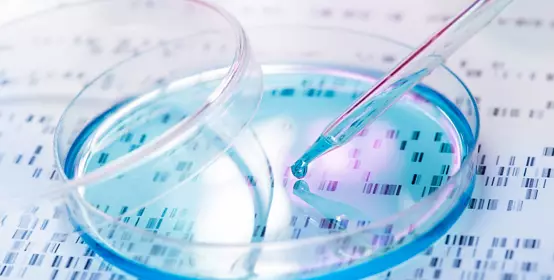
DNA sample being pipetted into petri dish with DNA gel in background.

Single-use Bioprocessing Bags
Advanced Polymers for Single-use Bioprocessing Bags
Our advanced polymers for single-use bioprocessing bags are designed for the unique needs of contact and tie layers in bioprocessing film structures. Quality, control and consistency are absolutely essential to the biopharma industry. The same holds true for the single-use bioprocessing bags used to develop and produce biopharmaceutical products.
Researchers and manufacturers need to know that their formulations are safe and secure, that processing will be clean and efficient and that the results will make it from the lab to consumers as quickly as possible. That's why our diverse portfolio of polymers are the highest quality, ideal for single-use bioprocessing bags.
Multi-layer Film Structure to Address Bioprocessing Bag Challenges
Decades of material science expertise and multi-layer film structure development allow us to offer polymers that address the challenges of bioprocessing bags from the inside out:
- Advanced contact layer resins optimized for cleanliness and excellent sealing properties
- A broad range of tie layer materials for adhesion to nylon and ethylene vinyl alcohol (EVOH), as well as many other substrates
- DOW™ HEALTH+™ offerings for critical layers of the structure
- Globally available products to simplify regional development
- Gamma irradiation stability

Offering advanced sealant performance along with exceptional clarity, gloss and abuse resistance for complex film structures.

Combine excellent toughness, flexibility and resilience with the high levels of cleanliness and sealability needed for biopharmaceutical film applications.


Helping produce strong, functional bonds with polyethylene and a wide range of other substrates, including nylon and ethylene vinyl alcohol (EVOH).

Featuring low temperature sealing, flexibility, puncture resistance and more for excellent performance as tie layers.

Proven polyethylene (PE) resin solutions…plus
All of our medical grade polymers offer excellent performance and value, but DOW™ HEALTH+™ Polymers deliver something extra.
These proven polyethylene (PE) resins are specifically designed to meet the stringent requirements of bioprocessing films and other healthcare-related applications. Their high levels of quality and consistency are backed by our HEALTH+™ service offering, which includes but is not limited to:
- Secure, global product supply
- 1-year notification of change (NOC) + 1-year right to buy
- Drug master file (DMF) listings
- USP Class VI and/or EU Pharmacopeia
- USP <661.1>
In addition to helping reduce your workload, these added benefits can help speed up the biopharma development process.

Protection you can count on
Your one-stop shop for contact and tie layer resins.
Bioprocessing films
Explore proven, pre-approved materials for bioprocessing films and more.
We’re ready to help answer your bioprocessing bag challenges.
New products, news, events, and more delivered to your inbox.


